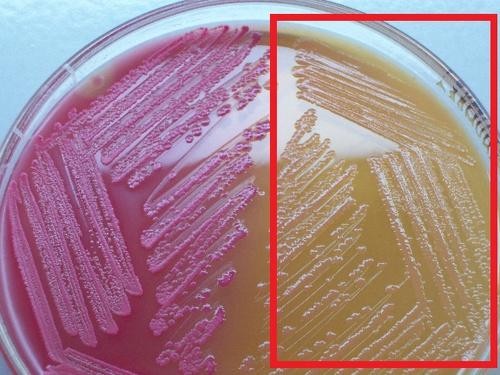
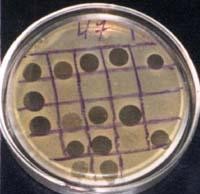
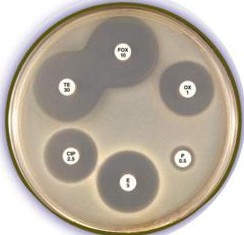

Материал: Литусов_Пиогенные кокки

Рисунок 1.30 – Панариций. Заимствовано из Интернет-ресурсов.
Фурункул (лат. furunculus) - острое гнойно-некротическое воспаление волосяного мешочка и окружающей ткани (рисунок 1.31).


Рисунок 1.31 – Схема образования и внешний вид фурункула. Заимствовано из Интернет-ресурсов.
Фурункул часто начинается с фолликулита – поражения волосяного фолликула без вовлечения в процесс окружающих участков кожи и глубоких тканей. Фурункулы формируются в местах локализации волосяных фолликулов (лицо, шея, подмышечные впадины, бедра). При этом стафилококковая инфекция может распространяться на апокриновые потовые железы (открывающиеся не на поверхность кожи, а в волосяные фолликулы) в подмышечной впадине или паховой области с развитием гнойных гидраденитов (рисунок 1.32).

Рисунок 1.32 – Гнойный гидраденит. Заимствовано из Интернет-ресурсов.
В некоторых случаях возможны множественные фурункулы – фурункулез (рисунок 1.33).


Рисунок 1.33 – Множественные фурункулы. Заимствовано из Интернет-ресурсов.
Карбункул (лат. carbunculus - уголёк) - острое гнойно-некротическое воспаление кожи и подкожной клетчатки вокруг группы волосяных фолликулов и сальных желёз (рисунок 1.34).


Рисунок 1.34 – Схема образования и внешний вид карбункула. Заимствовано из Интернет-ресурсов.
Абсцесс (abscessus – нарывать) – полость, заполненная гноем и отграниченная от окружающих тканей фибриновой оболочкой (рисунок 1.35).


Рисунок 1.35 – Схема образования и внешний вид абсцесса. Заимствовано из Интернет-ресурсов.
Осложнением стафилококковых абсцессов могут быть бактериемия и септикопиемия с последующим поражением многих органов.
Остеомиелит – это острое или хроническое воспалительное заболевание костей, возникающее чаще всего в результате гематогенного заноса возбудителя (рисунок 1.36).

Рисунок 1.36 – Остеомиелит. Заимствовано из Интернет-ресурсов.
Ангина (острый тонзиллит) – острое воспаление миндалин, сопровождающееся симптомами общей интоксикации организма (рисунок 1.37).

Рисунок 1.37 – Стафилококковая ангина. Заимствовано из Интернет-
ресурсов.
Синдром “ошпаренных младенцев” (болезнь Риттера) наблюдается у новорожденных, инфицированных штаммами, продуцирующими эксфолиативный токсин. Заболевание начинается бурно, вначале появляются очаги эритемы на коже, через 2-3 суток на этих участках образуются большие пузыри (как при термических ожогах). После вскрытия пузырей обнажаются эрозированные участки (рисунок 1.38).

Рисунок 1.38 – Синдром ошпаренных младенцев. Заимствовано из Интернет- ресурсов.
Синдром ошпаренных младенцев возникает при инфицировании ребенка во время родов.
Синдром “ошпаренной кожи” (синдром Лайелла) наблюдается у детей старших возрастных групп и у взрослых. Он характеризуется появлением очагов эритемы и пузырей, тяжелой интоксикацией и отслоением субэпидермального слоя (рисунок 1.39).

Рисунок 1.39 – Синдром ошпаренной кожи. Заимствовано из Интернет-ресурсов.
Синдром токсического шока развивается при инфицировании штаммами, продуцирующими токсин TSST-1. Впервые описан в 1980 г. у женщин, пользующихся сорбирующими тампонами в период менструаций. Заболевание проявляется высокой температурой, снижением артериального давления, развитием шока.
Пищевые отравления стафилококковой этиологии проявляются рвотой, болями в животе, водянистой диареей уже через 2-6 часов после употребления в пищу инфицированных продуктов (кондитерских изделий с кремом, молочных продуктов, консервов в масле, мясных и овощных салатов и др.). Устойчивость стафилококков к высоким концентрациям поваренной соли позволяет им долго сохраняться в различных пищевых продуктах. Пищевые отравления чаще вызывают энтеротоксины типов А и D.
Особое место занимают инфекции, связанные с оказанием медицинской помощи (ИСМП) и обусловленные коагулазонегативными стафилококками, в частности, S. epidermidis. Эти бактерии являются маловирулентными, но способны вызывать инфекции у лиц с ослабленной резистентностью организма. Развивающиеся при этом инфекции имеют следующие особенности:
вялое течение (между заражением и первыми симптомами отмечается длительный инкубационный период);
в большинстве случаев заболевание развивается как внутрибольничная инфекция;
возбудитель инфекции обладает в большинстве случаев множественной устойчивостью к антибиотикам;
большинство инфекций, обусловленных коагулазонегативными стафилококками, связано с имплантацией медицинских устройств (катетеров, протезов и др.).
Основными факторами патогенности коагулазонегативных стафилококков – возбудителей ИСМП являются поверхностные адгезины, способствующие
прикреплению бактерий к инородным устройствам и их колонизации (полисахаридный адгезин, экзополисахарид, формирующий слизистый слой на поверхности инородного материала).
Лабораторная диагностика стафилококковых инфекций. Основным методом диагностики стафилококковых инфекций является бактериологический (культуральный). Бактериоскопический метод имеет ориентировочное значение, так как он позволяет обнаружить грамположительные кокки, расположенные скоплениями в виде виноградной грозди. В качестве исследуемого материала используют гной, отделяемое ран, слизь, кровь, мочу. Вид исследуемого материала зависит от локализации патологического процесса. Исследуемый материал засевают на ЖСА (молочно-желточный солевой агар) и кровяной агар. Получив чистую культуру, устанавливают родовую и видовую принадлежность возбудителя с помощью следующих тестов:
продукция каталазы;
продукция лецитиназы;
ферментация глюкозы и маннита в анаэробных условиях;
продукция плазмокоагулазы;
наличие ДНКазы;
синтез фосфатазы;
чувствительность к новобиоцину;
гемолитическая активность.
При необходимости проводят определение чувствительности стафилококков к антибиотикам и фаготипирование культур.
Для выделения и количественного учета S. aureus в пищевых продуктах используют среду Байрда-Паркера. Среда содержит яичный желток для выявления лецитиназы, хлорид лития и теллурит калия для подавления роста сопутствующей микрофлоры, пируват натрия и глицин для стимулирования роста стафилококков. На среде Байрда-Паркера формируются черные колонии стафилококков, вокруг которых образуются характерные зоны опалесценции в результате разложения лецитиназой яичного желтка (рисунок 1.40).

Рисунок 1.40 – Рост золотистого стафилококка на среде Байрда-Паркера.
Заимствовано из Интернет-ресурсов.
Патогенные коагулазоположительные стафилококки (в частности, S. aureus) ферментируют маннит, а коагулазоотрицательные стафилококки не ферментируют маннит. Поэтому для выделения клинически значимых культур стафилококков из
пищевых продуктов используют солевой агар с маннитом и феноловым красным. Штаммы S. aureus на этой среде образуют желтые колонии и вызывают изменение розового цвета среды на желтый. Коагулазоотрицательные стафилококки образуют красные колонии без изменения цвета среды (рисунок 1.41).
Рисунок 1.41 – Рост коагулазоотрицательных (слева) и коагулазоположительных (справа) стафилококков на солевом агаре с маннитом. Заимствовано из Интернет- ресурсов.
Биохимическую активность стафилококков изучают с помощью коммерческих тест-систем (рисунок 1.42).

Рисунок 1.42 – Тест-система для определения биохимических свойств стафилококков. Заимствовано из Интернет-ресурсов.
Синтез фосфатазы стафилококков выявляют путем добавления в питательную среду паранитрофенилфосфата. После суточного инкубирования посевов в термостате у положительных культур вокруг колоний формируется желтая зона.
Определение чувствительности к новобиоцину осуществляется диско- диффузионным методом. Диаметр зоны задержки роста более 16 мм свидетельствует о чувствительности культуры, а менее 16 мм – о резистентности культуры.
Для изучения фагочувствительности стафилококков используют набор из 23 бактериофагов (рисунок 1.43).

Рисунок 1.43 – Бактериофаги стафилококковые диагностические. Заимствовано из Интернет-ресурсов.
Этот набор позволяет провести фаготипирование выделенных штаммов (определить фаговар), то есть осуществить эпидемиологическое маркирование выделенной культуры (рисунок 1.44).
Рисунок 1.44 – Фаготипирование стафилококков. Заимствовано из Интернет- ресурсов.
Чувствительность к антибиотикам проверяют стандартным диско- диффузионным методом (рисунок 1.45).
Рисунок 1.45 – Определение чувствительности стафилококков к антибиотикам диско-диффузионным методом. Заимствовано из Интернет-ресурсов.
Для эпидемиологического маркирования штаммов изучают также плазмидный профиль выделенных культур. Стафилококки имеют плазмиды различной молекулярной массы. Изоляты стафилококков, содержащие плазмиды, как правило, обладают множественной устойчивостью к антибиотикам.
Лечение стафилококковых инфекций. Поверхностные стафилококковые инфекции (пиодермии) чаще всего лечатся с помощью препаратов для местного применения: бриллиантового зеленого, фукорцина, калия перманганата и других средств. Для лечения глубоких стафилококковых инфекций используют антибиотики. При необходимости предварительно определяют чувствительность выделенных культур к антибиотикам диско-диффузионным методом.
В лечении стафилококковых инфекций применяют также стафилококковый бактериофаг (рисунок 1.46), антистафилококковый иммуноглобулин (рисунок 1.47) и другие препараты.


Рисунок 1.46 – Стафилококковый бактериофаг. Заимствовано из Интернет-ресурсов.

Рисунок 1.47 – Антистафилококковый иммуноглобулин. Заимствовано из Интернет- ресурсов.
Профилактика стафилококковых инфекций. Эффективных средств специфической профилактики стафилококковых инфекций не разработано. Неспецифическая профилактика заключается в соблюдении санитарно- гигиенического и противоэпидемического режима, применении современных дезинфицирующих и антисептических средств, выявлении и санации бактерионосителей (особенно среди персонала хирургических стационаров и
родильных домов для профилактики инфекций, связанных с оказанием
медицинской помощи). Для санации носителей метициллин-резистентных штаммов
S. aureus используют интраназальное применение антибиотика мупироцина.
Вопросы для контроля усвоения материала
Таксономическое положение, морфологические, тинкториальные и биохимические свойства стафилококков.
Факторы патогенности стафилококков.
Источник инфекции, механизмы и пути передачи инфекции при стафилококковых заболеваниях.
Клинические проявления стафилококковых инфекций.
Диагностика, профилактика и лечение стафилококковых инфекций.
Тренировочные тесты
Стафилококки относятся к семейству (один правильный ответ):
Vibrionaceae
Staphylococcaceae
Pseudomonadaceae
Bacillaceae
Streptococcaceae
S. aureus относится к роду (один правильный ответ):
Spirillum
Streptococcus
Staphylococcus
Shigella
Salmonella
Родовое название Staphylococcus отражает следующие признаки (один правильный ответ):
тинкториальные свойства
физиологические особенности
генетические особенности
морфологические свойства
экологические особенности
Видовое название золотистого стафилококка (S. aureus) отражает следующие признаки (один правильный ответ):
тинкториальные свойства
культуральные особенности
морфологические свойства
экологические особенности
патогенность
К стафилококкам относятся следующие виды (несколько правильных ответов):
S. sonnei
S. typhi
S. aureus
S. flexneri
S. saprophyticus
В мазке стафилококки располагаются в виде (один правильный ответ):
одиночных палочек
цепочек палочек
виноградной грозди
цепочек кокков
тетракокков
Цвет стафилококков при окраске по Грамму (один правильный ответ):
красный
синий
черный
зеленый
желтый
Характерные признаки стафилококков (несколько правильных ответов):
грамотрицательные кокки
грамположительные кокки
неподвижные бактерии
строгие анаэробы
факультативные анаэробы
К признакам, общим для стафилококков и стрептококков, относятся (несколько правильных ответов):
отсутствие спорообразования
наличие цитохромов
каталазная активность
сферическая форма клеток
положительная окраска по Граму.
Для эпидермального стафилококка характерны следующие признаки (несколько правильных ответов):
наличие фосфатазы
способность аэробно расщеплять манит
наличие плазмокоагулазы
способность к гемолизу
наличие чувствительности к новобицину
Для S. saprophyticus характерны следующие признаки (один правильный ответ):
наличие фермента ДНКазы
способность расщеплять сахарозу
наличие плазмокоагулазы
наличие фосфатазы
способность к гемолизу